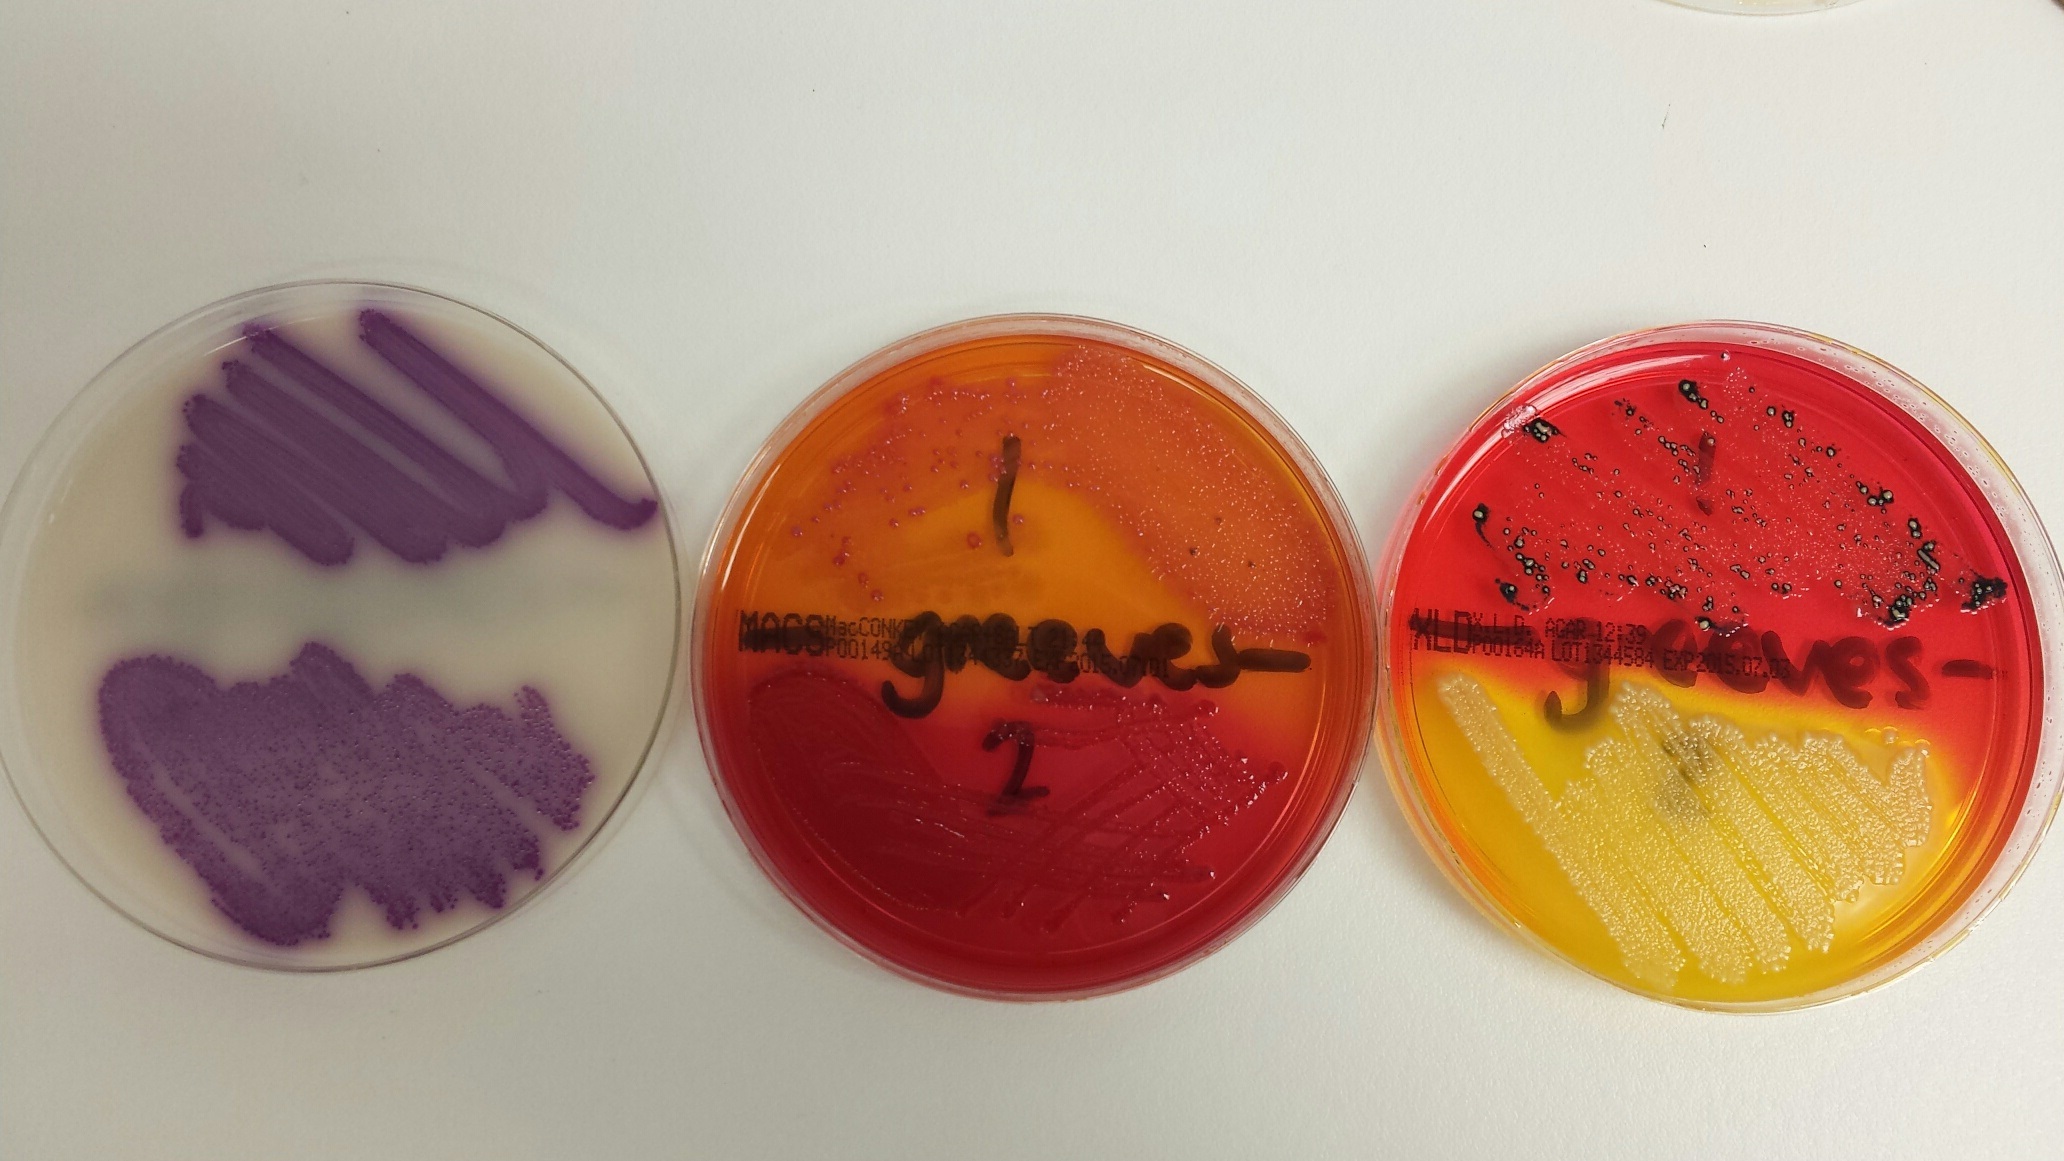
Salmonella in Game Birds F1

There are over 2,500 types of Salmonella bacteria and most of these do not cause disease (except in young birds under stress). The most common isolate of Salmonella in gamebirds in a recent survey was S binza with around 30-50% of isolates, but the significance of this is doubtful.
S typhimurium and S enteritdis can also be isolated and these are more likely to cause disease. Birds over 4 weeks of age usually show no signs of the disease but they can be carriers and responsible for spread of the bacteria, usually through faeces. After an increase in cases of Salmonella between 1993 and 1997, numbers have now decreased again. Mortality tends to be in the first 2-3 weeks as younger birds have not developed their normal gut flora and this can allow Salmonella to colonize the gut and enter the blood stream. This can result in diarrhoea and septicaemia with up to 100% mortality in some cases. Survivors of Salmonella are typically stunted. Salmonella may also be a cause of yolk sac infection, and therefore clean egg production and hatchery hygiene is paramount.
Clinical Signs
Diarrhoea (often yellow) is a clinical sign of Salmonella, as is a lack of appetite in the bird, dejection and ruffled feathers, thirst and a reluctance to move. Sudden death may also occur.
Post Mortem Findings
Post mortem lesions would typically be yolk sac infection in young chicks, older birds can exhibit nodules in the wall of caeca and large intestine, caseous caecal cores, nodules in the lungs and fine foci of liver necrosis-white spots in the liver.
Diagnosis
Diagnosis of Salmonella can be done through isolation and identification of the bacteria from samples taken from affected birds. The initial bacterial growth is 'typed' to a salmonella group and then 'serotyped' into the specific strain and this can take some time. There is great variance between strains in the ability to cause disease with some causing massive mortality and other strains being an incidental finding in otherwise healthy birds - your vet can advise on the relative significance of each strain and possibly the likely source.
Fig 1 Differing appearance of salmonella bacteria on culture plates
Treatment and Control
Appropriate antibacterial treatment in drinking water if considered necessary and electrolytes, coupled with good overall hygiene levels and husbandry are methods of control of Salmonella. Even after treatment some birds can remain carriers and potential sources of infection. This good husbandry includes hatchery hygiene, good site biosecurity, clean egg production and brooder hygiene. Obtaining hatching eggs, day old chicks and poults from reputable sources is also important.

Fig 2 Bad husbandry - Dry drinkers causing dehydration in birds
Biosecurity
All Salmonellae are potentially infective to humans and other species of animals and therefore it is paramount to practice good biosecurity if Salmonella is diagnosed. Your veterinary surgeon is the point of contact to advise on this.

Fig 3 Example of a well set up rearing shed

Fig 4 Optimum nutrition provides better egg condition

Fig 5 Good site biosecurity



